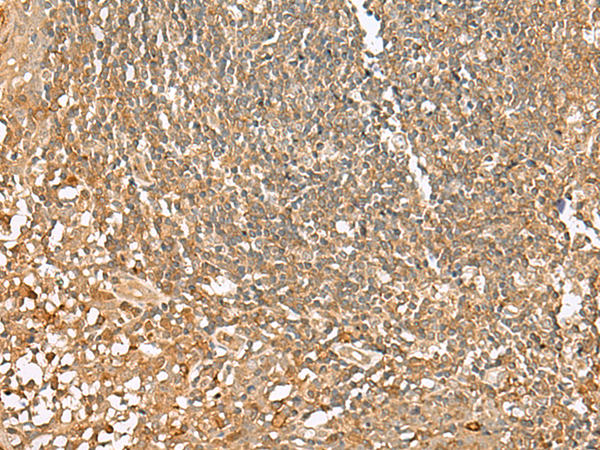

提醒成功

搜索
Rabbit Polyclonal Antibody to SCRN2
-
货号:
P02906 -
别名:
Ses2 -
应用:
WB,IHC -
反应种属:
Human, Mouse, Rat -
抗体类型:
Primary antibody -
Swissprot:
Q96FV2 -
规格:
-
数量:
-+ -
说明书:
目录价¥1980

Rabbit Polyclonal Antibody to SCRN2
Description |
|---|
SCRN genes encode protein members of the secernin family including Secernin 1, Secernin 2 and Secernin 3. Function of Secernin 2 and Secernin 3 are so far not well understood. Secernin 1 is a novel 50-kDa cytosolic protein that appears to be involved in the regulation of exocytosis from peritoneal mast cells. Secernin-1 a novel tumor-associated antigen (TAA) and may be a universal marker of different cancer types including gastric cancer, which has been validated by several researches. Measurement of SCRN1 can be used in the early detection of cancer or in the surveillance of patients who undergo surgery. |
Specification |
|
|---|---|
| Aliases | Ses2 |
| Swissprot | Q96FV2 |
| WB Predicted band size | 47 kDa |
| Host/Isotype | Rabbit IgG |
| Antibody Type | Primary antibody |
| Storage | Store at 4°C short term. Aliquot and store at -20°C long term. Avoid freeze/thaw cycles. |
| Species Reactivity | Human, Mouse, Rat |
| Immunogen | Fusion protein of human SCRN2 |
| Formulation | Purified antibody in PBS with 0.05% sodium azide and 50% glycerol. |
Application |
|
|---|---|
| WB | 1/500-1/2000 |
| IHC | 1/50-1/300 |
| ELISA | 1/5000-1/10000 |
Product Image
- Gel: 8%SDS-PAGE, Lysate: 40 μg, Lane: Mouse small intestines tissue lysate, Primary antibody: P02906(SCRN2 Antibody) at dilution 1/350, Secondary antibody: Goat anti rabbit IgG at 1/8000 dilution, Exposure time: 10 seconds
- The image is immunohistochemistry of paraffin-embedded Human esophagus cancer tissue using P02906(SCRN2 Antibody) at dilution 1/50. (Original magnification: ×200)
- The image is immunohistochemistry of paraffin-embedded Human tonsil tissue using P02906(SCRN2 Antibody) at dilution 1/50. (Original magnification: ×200)
For Reseach Only
Application Key:WB - Western Blot | IHC - Immunohistochemistry | ICC - Immunocytochemistry | FCM - Flow Cytometry | ELISA - Enzyme-linked Immunosorbent Assay | IP - Immunoprecipitation
#P02906

相关产品















 微信/QQ登录
微信/QQ登录


 首页
首页